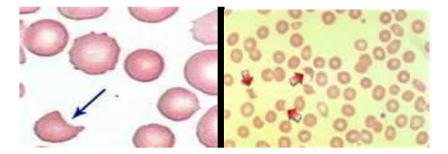

1. NGUYÊN LÝ
Hiện tượng tự miễn tuyến giáp thường gặp ở phụ nữ. Nồng độ kháng thể (KT) ở phụ nữ tăng theo tuổi, tăng từ khoảng 10% ở tuổi 18-24 đến 30% ở tuổi 55-65 đối với TgAb. Phương pháp dựa trên nguyên lý định lượng miễn dịch phóng xạ cạnh tranh (RIA). Trong quá trình ủ KT kháng Tg đơn dòng pha rắn cạnh tranh với tự KT kháng Tg của mẫu cần đo ở những vị trí đặc hiệu có gắn 125I (tracer). Sau khi hút khô và rửa, hoạt độ phóng xạ ở ống nghiệm được đo bằng máy đo
gamma. Mức độ gắn sẽ tỷ lệ nghịch với nồng độ tự KT kháng Tg của mẫu.
2. CHUẨN BỊ
2.1. Người thực hiện
- Bác sỹ chuyên ngành Y học hạt nhân
- Kỹ thuật viên xét nghiệm RIA
- Kỹ sư, kỹ thuật viên vận hành thiết bị đo mẫu
- Cán bộ hóa dược phóng xạ
2.2. Phương tiện, hóa chất
2.2.1. Phương tiện
- 2 máy đo Gamma Counter đo 125I và xử trí mẫu tự động theo chương trình.
- 2 máy lắc ngang ( 200-350 vòng/phút,thường dùng 300 vòng/phút),
- 2 máy trộn.
- Một giá cắm bộ micropipet có số hút 20 l , 200 l, 1000 l và các hộp đựng đầu plastic các loại.
- Giá cắm ống nghiệm .
2.2.2. Hóa chất
RIA kít định lượng AnTg nhập của hãng. Thành phần kit gồm:
Hóa chất đủ cung cấp cho 100 lần định lượng. Bảo quản kit và hóa chất ở 2-8 oC. Thời gian sử dụng của mỗi hóa chất ghi trên nhãn.
Chất đánh dấu phóng xạ (tracer): 1 lọ chứa chứa 22 ml Tg gắn iod, màu đỏ. HTPX 137 kBq mỗi ống. Chất bảo quản NaN3 (<0,1%).
Chuẩn 0 (Calibrator 0): 1 lọ chứa 4,2 ml, chất bảo quản NaN3 (<0,1%), pha sẵn
Chuẩn 1-5 (Calibrator 1-5): 5 lọ chứa 0,7 ml anti-Tg (huyết thanh người). Để có giá trị chính xác, đối chiếu với giá trị viết trên tờ dữ liệu kiểm tra chất lượng. Chất bảo quản NaN3 (<0,1%).
HTKT (Controls): 2 ống chứa 0,7ml anti-Tg (ht người). Để có giá trị chính xác, hãy tham khảo giá trị viết trên tờ dữ liệu kiểm tra chất lượng. Chất bảo quản NaN3 (<0,1%).
Các ống nghiệm tráng KT: 100 ống nghiệm tráng KT đơn dòng của chuột kháng Tg. Những ống không sử dụng phải bảo quản ở 2-8oC, tránh ẩm.
Dung dịch rửa (cô đặc 50 lần): 1 lọ 20ml đệm tris-HCl cùng với thuốc tẩy và chất bảo quản NaN3 (<0,1%). Pha thành 1.000ml với nước cất. Dung dịch rửa pha loãng để được 2 tháng ở 2-8 oC.
Để đạt được kết quả tốt, những điều sau đây phải được tôn trọng:
+ Không trộn hóa chất ở các lô khác nhau.
+ Không sử dụng hóa chất quá thời hạn sử dụng.
+ Hãy sử dụng các đồ thuỷ tinh được lau sạch sẽ.
+ Hãy sử dụng nước cất được bảo quản trong các container sạch.
+ Tránh mọi sự ô nhiễm các mẫu; sử dụng đầu hút nhựa mới dùng một lần cho các mẫu và hóa chất.
Tất cả hóa chất phải đưa về nhiệt độ phòng (18-250C) ít nhất 30 phút trước khi sử dụng.
3. CHỈ ĐỊNH
Tất cả các người bệnh có bênh liên quan đến tuyến giáp.Đặc biệt trong chẩn đoán, theo dõi tiến triển của bệnh sau điều trị ung thư tuyến giáp trạng thể biệt hóa bằng 131I.
4. CHỐNG CHỈ ĐỊNH
Không có .
5. CÁC BƯỚC TIẾN HÀNH
5.1. Lấy bệnh phẩm
Người bệnh cần nhịn ăn sáng,được lấy1-2 ml máu tĩnh mạch không chống đông.
5.2. Tiến hành kỹ thuật
Chuẩn bị huyết thanh người bệnh:
Người bệnh cần nhịn ăn sáng,được lấy1 ml máu tĩnh mạch không chống đông. Sau khi lấy mẫu máu, huyết thanh được tách bằng phương pháp thông thường. Tiến hành định lượng ngay hoặc bảo quản đến 24h ở 2-8oC. Thời gian bảo quản lâu hơn nên để ở -20oC, thích hợp hơn là chia đều,tránh làm đông lặp đi lặp lại và tránh làm tan đông. Sau khi làm tan đông, mẫu huyêt thanh phải được trộn cẩn thận.
Cảnh báo và đề phòng: Các vật liệu thô có nguồn gốc từ người chứa trong hóa chất của kit này đã được kiểm định với các kit được cấp phép và đã xác định âm tính với KT kháng HIV1, HIV2, HCV và kháng nguyên HbsAg. Tuy nhiên cũng không thể đảm bảo hoàn toàn là những sản phẩm như vậy sẽ không truyền viêm gan, virus HIV hoặc bất kỳ virus nào khác, tất cả các vật liệu thô có nguồn gốc người có trong mẫu được định lượng phải được xử trí như tác nhân có tiềm năng nhiễm trùng. Bởi vậy, các chất thải của thử nghiệm phải được khử ô nhiễm và loại bỏ theo như các qui định đã ban hành. Các vật liệu dễ cháy dùng một lần phải được đốt thành tro; các vật liệu không dễ cháy dùng một lần phải được khử trùng trong nồi hấp ít nhất 1 h ở 121oC. Chất thải lỏng phải được trộn với sodium hypochlorite ở nồng độ cuối cùng là 3%. Để hypochlorite tác dụng trong ít nhất là 30 phút. Chất thải lỏng chứa acid phải được trung hoà bằng lượng base thích hợp trước khi xử trí với sodium hypochlorit.
+ Tránh làm đổ tung toé và tạo thành các hạt sương; trong trường hợp bị đổ, hãy rửa sạch bằng dung dịch sodium hypochlorit 3% và loại bỏ dung dịch này như là một chất thải có khả năng nhiễm trùng.
+ Một số hóa chất chứa sodium azid là chất bảo quản; để tránh tạo thành các azide kim loại gây nổ ở những que thăm bằng chì, đồng, các hóa chất nên được loại bỏ bằng xả nhiều nước.
Quy trình định lượng:
+ Đưa tất cả các hóa chất và mẫu về nhiệt độ phòng 30 phút trước khi sử dụng.
+ Trước khi dùng trộn mẫu nhẹ nhàng.
+ Đối với tất cả các máy chuẩn liều nên đo mẫu kép.
Dùng ống nghiệm thường để đo tổng xung và ống nghiệm có tráng KT để đo mẫu và HTKT.
Nhỏ 20 l chuẩn, HTKT, mẫu vào các ống nghiệm tương ứng.
Thêm 200 ll tracer vào tất cả các ống nghiệm.
Trộn các ống nghiệm trên máy trộn và ủ 90 phút ở nhiệt đọ phòng trên máy lắc với 150 v/p.
Đổ, úp khô các ống nghiệm, trừ ống đo tổng xung.
Thêm 2 ml dung dịch rửa pha loãng vào mỗi ống nghiệm trừ ống đo tổng. Hút khô hoặc đổ, úp khô trên giấy thấm.
Đo hoạt độ phóng xạ phần liên kết trong 1 phút bằng máy đo gamma. Nên kiểm tra phông của thiết bị trước khi định lượng. Để tránh biến đổi độ nhậy hệ thống, phông phải được giảm đến mức tối thiểu hoặc điều chỉnh cho phù hợp.
LƯU Ý: nếu giá trị anti-Tg cao (>2.000UI/ml) với các mẫu của người bệnh thì mẫu gốc nên được pha loãng. Dùng chuẩn 0 để pha loãng, không được dùng dung dịch đệm.

+ Trộn và ủ: 90 phút nhiệt đọ phòng, trên máy lắc (150 v/p).
+ Hút và rửa: 1x 2ml.
+ Đo.
6. NHẬN ĐỊNH KẾT QUẢ

Vẽ đường cong chuẩn theo thang chia log bằng cách đánh dấu % B/Bo thu được với mỗi chuẩn (trục y) dựa vào nồng độ tương ứng (trục x). Tính toán % B/Bo của mỗi mẫu và đọc nồng độ anti-Tg bằng IU/ml bằng phép nội suy trên đường cong chuẩn (định lượng).
VÍ DỤ VỀ TÍNH TOÁN
Các giá trị dưới đây chỉ được xem như là ví dụ, không được dùng trong dữ liệu thực nghiệm.

CÁC GIÁ TRỊ THAM CHIẾU
Mỗi labo nên xác định một giá trị tham chiếu của riêng mình.
Các giá trị dưới đây chỉ là để tham khảo.
< 30 IU/ml | âm tính |
30-70 IU/ml | Bình thường |
>70 IU/ml | Dương tính |
6. CHỐNG CHỈ ĐỊNH
Không có.
7. CÁC BƯỚC TIẾN HÀNH
- Đưa thuốc thử và mẫu bệnh phẩm ra nhiệt độ phòng (18-25oC) tối thiểu 30’ trước khi dùng.
- Đánh số kép lên các ống nghiệm (Total, Chuẩn (Standards - St), huyết thanh giám sát (Control serum - CS), bệnh phẩm - P).
- Trộn đều thuốc thử, mẫu chuẩn… tránh bọt.
- Lấy bệnh phẩm: 0,3 mL huyết thanh.
- Tiến hành kỹ thuật:
+ Cho 50 µl huyết thanh chuẩn (Standard), huyết thanh giám sát (Control cesum), bệnh phẩm vào các ống thử nghiệm tương ứng.
+ Cho 300 µl kháng thể kháng Insulin đánh dấu 125I (Tracer) vào tất cả các ống, kể cả ống T, đậy kín bằng giấy parafilm.
+ Lắc ngang (250-300 v/phút), ủ 2h ở nhiệt độ phòng.
+ Rửa 3 lần như sau:
. Dốc ống ít nhất 2 phút.
. Cho 1 ml dung dịch rửa, dốc ống ít nhất 2 phút (lần 1).
. Lặp lại thêm 2 lần như trên.
+ Đo trên máy đếm Gamma , tính kết quả Bo/T và B/T.
TRỊ SỐ BÌNH THƯỜNG
Phải làm trị số bình thường của mỗi Labo, trị số trên 68 mẫu serum người bình thường do hãng CIS-Bio cung cấp là:
Plasma: 2 – 17 µIU/mL tức 0,08 – 0,7 ng/mL.
PHA LOÃNG
Những mẫu vượt chuẩn cao sẽ được pha với Standard O (hệ số lần lượt 1/2, 1/5, 1/10)
ĐỘ ĐẶC HIỆU
Phản ứng chéo với:
Pork insulin 100%
Bovine insulin 100%
Rat insulin <0,03%
Split 32-33 proinsulin <0,0004%
Split 65- 66 proinsulin 100%
Des 31,32 proinsulin <0,0004%
Des 64,65 proinsulin 100%
C-Peptid <0,003%
Glucagon <0,0001%
ĐỘ NHẠY:
Nồng độ nhỏ nhất khác zero được phát hiện với xác suất 95% là 0, 2 µIU/mL (8 pg/mL).
HOOK EFFECT:
Không có hook effect ở nồng độ <60.000 µIU/mL.
BẢNG TÓM TẮT QUY TRÌNH

8. NHỮNG SAI SÓT VÀ XỬ TRÍ
8.1. Sai xót chủ quan & khách quan
- Cho mẫu huyết thanh hoặc kháng nguyên phóng xạ vào các ống nghiệm bị bỏ sót.
- Độ chênh lệch số xung phóng xạ giữa hai ống kép chênh lệch nhau > 10% (CV > 10%) do sai xót khi đưa mẫu hoặc kháng nguyên hay kháng thể gắn phóng xạ vào ống nghiệm.
- Sai lệch thể tích của Micropipet; Hoạt độ riêng của chất đánh dấu phóng xạ với kháng nguyên & kháng thể thấp hơn quy chuẩn.
- Số xung đo phông của các giếng đếm phóng xạ cao và không ngang bằng nhau.
8.2. Khắc phục
- Tập trung khi triển khai làm, sau khi cho mẫu xong cần đưa ống nghiệm cao ngang tầm mắt để quan sát đáy các ống để bổ xung mẫu bỏ sót.
- Những mẫu có CV>10% phải tiến hành làm lại; Định kì phải kiểm chuẩn độ chính xác của Micropipet; Triển khai định kỳ nội kiểm và ngoại kiểm với các lab trong nước và trên thề giới; Kiểm tra hoạt độ thuốc phóng xạ với chất gắn và kiểm tra chất lượng thiết bị.
- Nồng độ chất cần định lượng quá cao không được ngoại suy mà nên pha loãng huyết thanh mẫu & định lượng lại để khắc phục “hiệu ứng móc”.
- Đăng nhập để gửi ý kiến